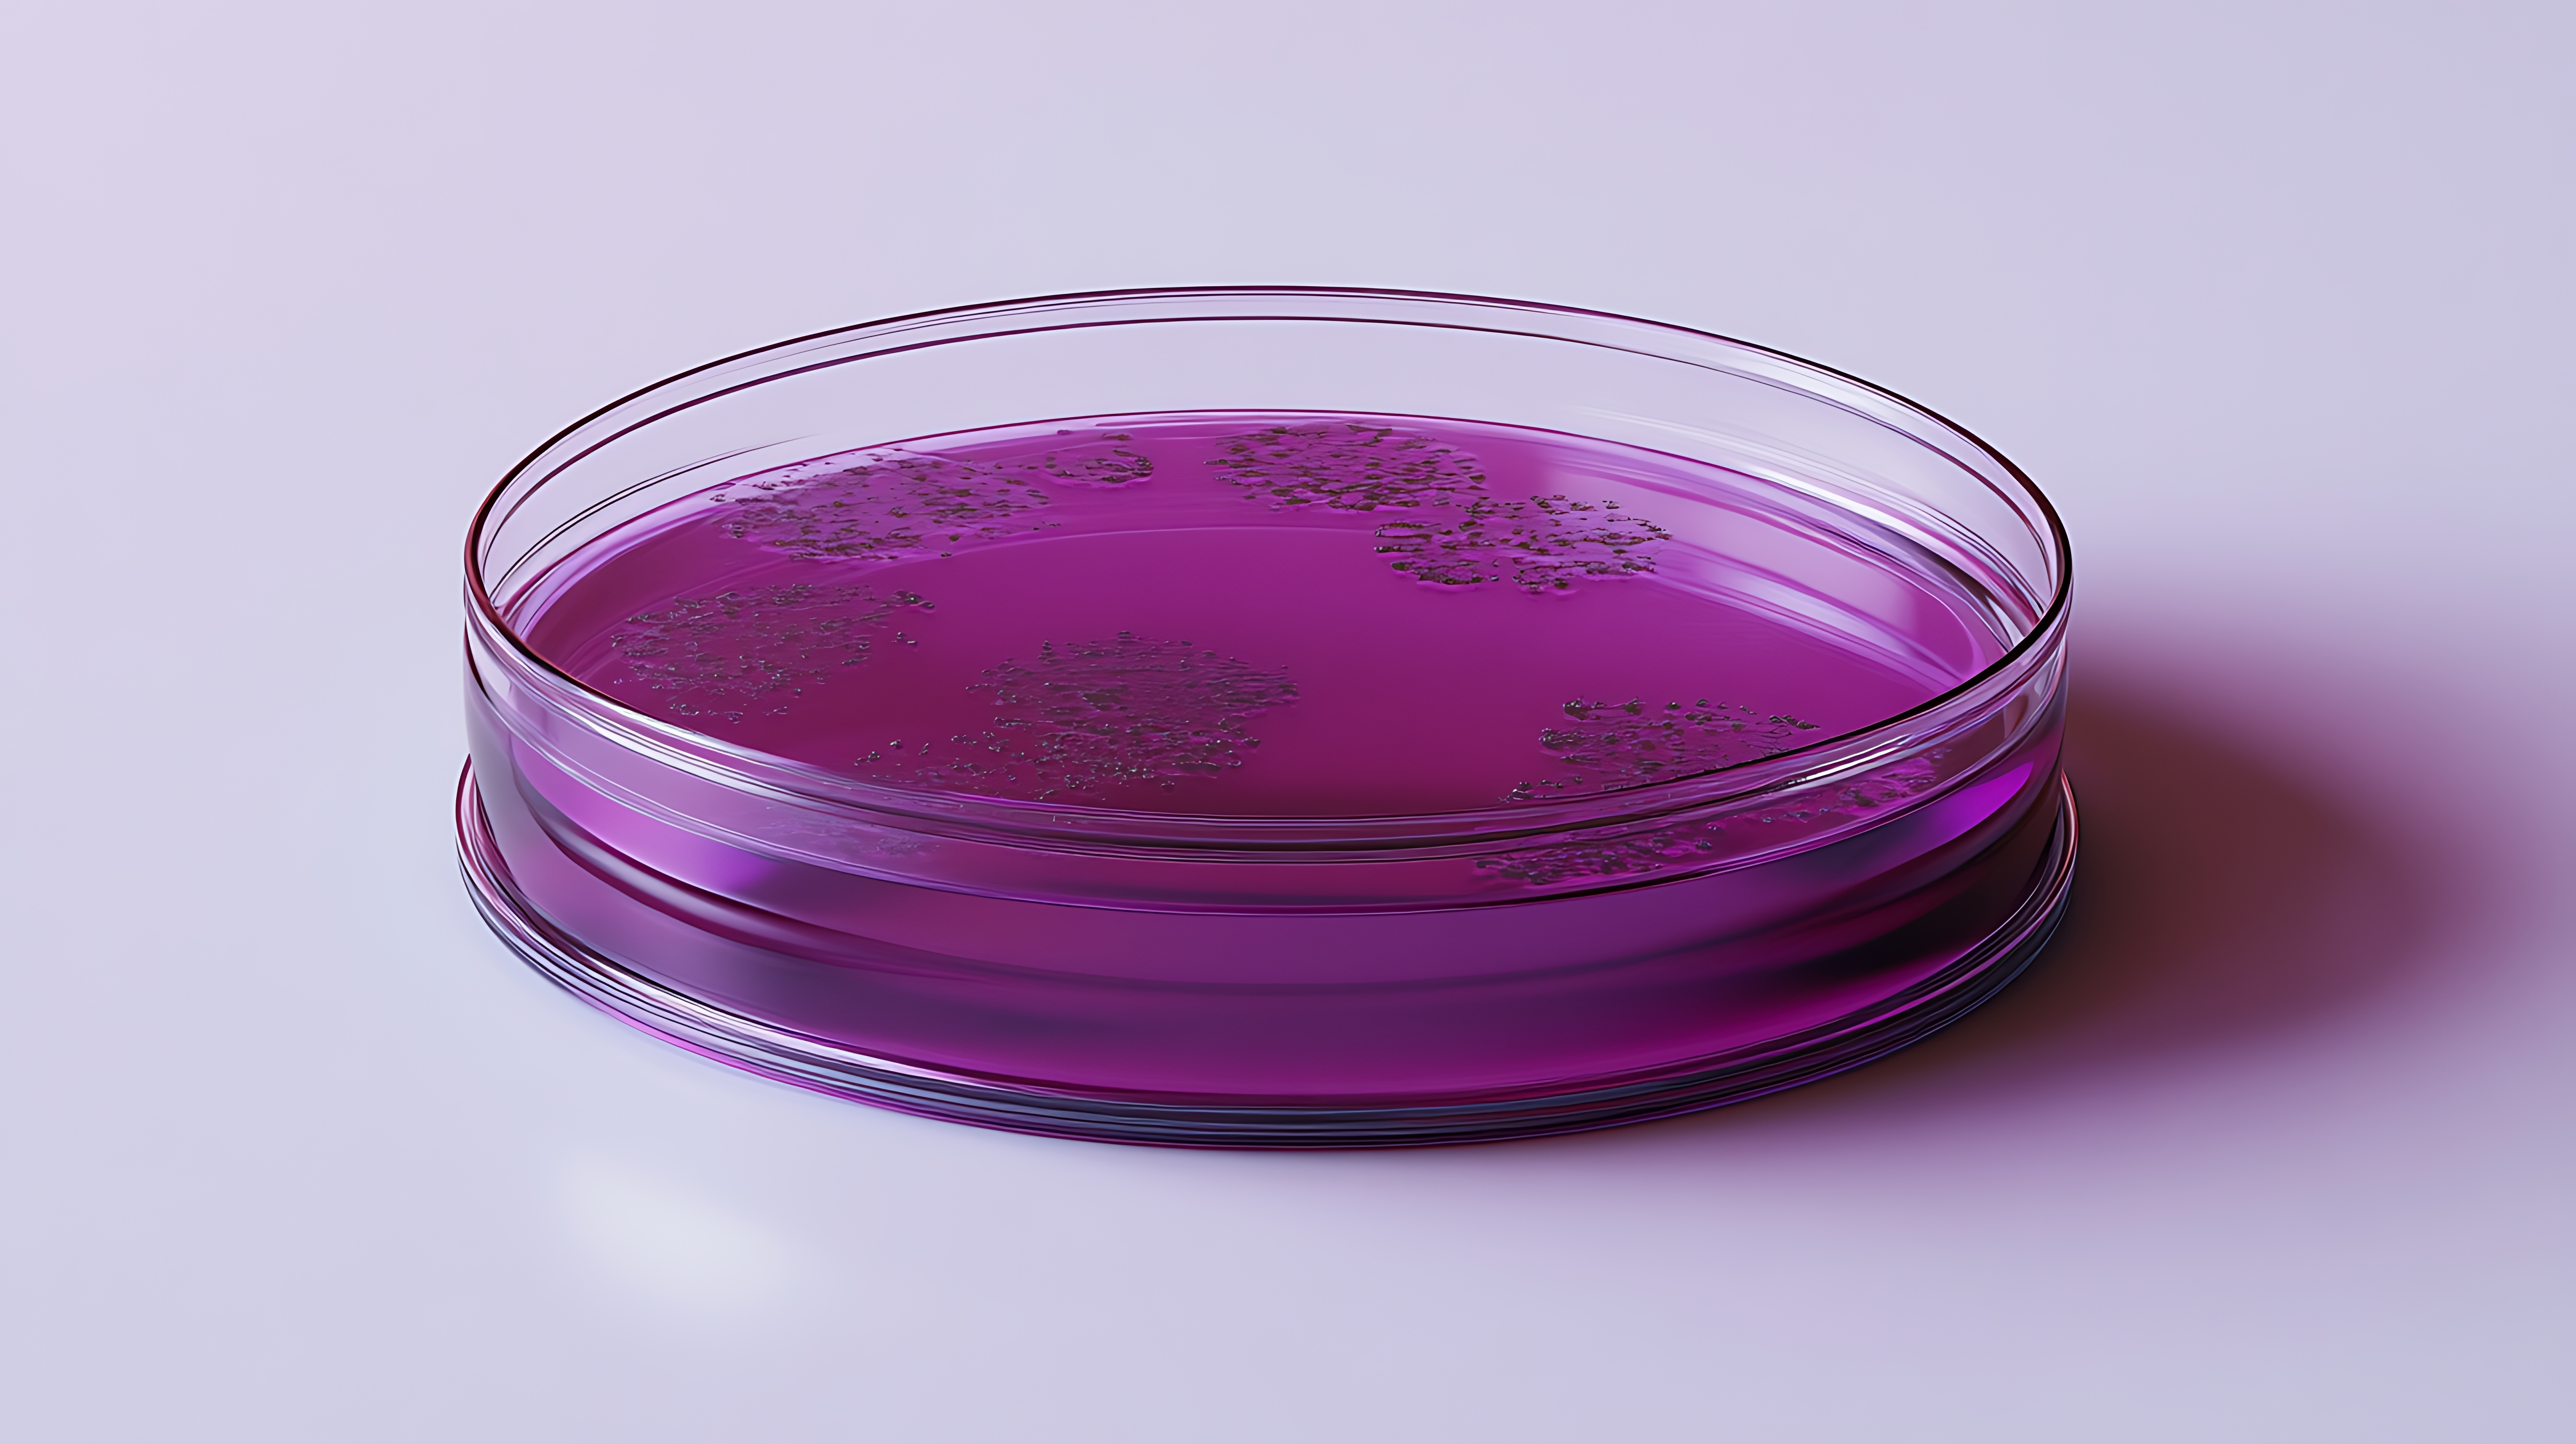
Faecal Streptococci

Using advanced MALDI-TOF technology, our experts can identify the presence of Faecal Streptococci in various water sample types. This is often carried out alongside a Faecal Coliform test to determine if the bacteria are of human or animal origin.
What is Faecal Streptococci?
Faecal Streptococci (Enterococci) are a group of coccoid bacteria naturally found in the stomachs and intestines of animals, such as birds, livestock, and humans. Many species of streptococci are pathogenic, causing diseases such as pneumonia, ear infections, and meningitis.
Like Faecal Coliforms, Faecal Streptococci are used as indicators for faecal pollution in water, making them a key contribution to water pollution research and management. They are also becoming a requirement for safe water analysis in potable and recreational applications, such as lakes used for swimming.
As Faecal Streptococci do not survive long outside of the body, their presence indicates that the pollution is recent. They usually survive slightly longer than E. coli, with studies showing they can persist for up to 12 weeks in moderate temperatures.
Our Faecal Streptococci Testing Services
The presence of Faecal Streptococci in water samples indicates faecal contamination, suggesting the presence of sewage or animal waste. If this is the case, the water supply is likely to contain a variety of microorganisms and pathogens that may be harmful, such as E. coli and Salmonella.
At ECT Water Microbiology, we offer comprehensive water testing services to identify if Faecal Streptococci numbers are over the safe limit using UKAS*-accredited methods and improved identification using state-of-the-art MALDI-TOF technology.
When tested alongside Faecal Coliforms, we can use the ratio of coliforms to streptococci and specific species detected to indicate whether the contamination is of animal or human origin. This is useful when trying to discover the source of the pollution.
Depending on the water source and the cause of contamination, different measures can be taken to improve the water quality.

Why Choose ECT Water Microbiology for Faecal Streptococci Testing?
- Water microbiology specialists
- 24 sample drop-off locations across the UK & Ireland
- UKAS*-approved, purpose-built laboratory
- Highly knowledgeable staff
- Secure & compliant sample handling
- Efficient analysis
- Reliable, accurate results
- 24/7 access to reports & data with the LabTrac app
* For a full list of our UKAS-accredited activities, please view our schedule of accreditation.













